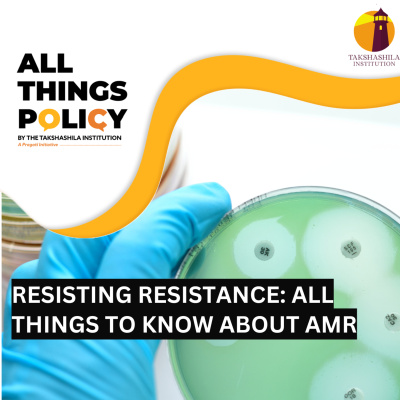
The Takshashila Podcast

The Takshashila Podcast
Resisting Resistance: All things to know about AMR
- Autor: Vários
- Narrador: Vários
- Editor: Podcast
- Duración: 0:39:04
- Mas informaciones
Informações:
Sinopsis
Vanshika and Shambhavi discuss the origin of Antimicrobial Resistance (AMR), mitigation strategies and possible ways forward for tackling AMR. All Things Policy is a daily podcast on public policy brought to you by the Takshashila Institution, Bengaluru. Find out more on our research and other work here: https://takshashila.org.in/ Check out our public policy courses here: https://school.takshashila.org.in